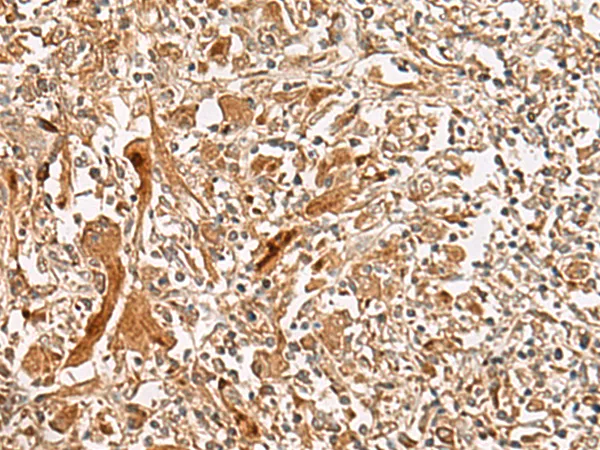
GCC2 Rabbit Polyclonal Antibody - image 1

GCC2 Rabbit Polyclonal Antibody
- Availability: 24/48H Stock Items & 2 to 6 Weeks non Stock Items.
- Dry Ice Shipment: No

GCC2 Rabbit Polyclonal Antibody
Description:
GCC2 rabbit polyclonal antibodyUniProt:
Q8IWJ2Gene Location:
9648Host:
RabbitReactivity:
Human, Mouse, RatClonality:
PolyclonalApplications:
IHCStability:
1 yearFragment:
IgGSymbol:
GCC2
